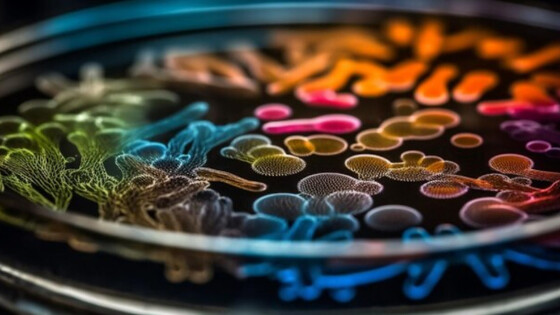
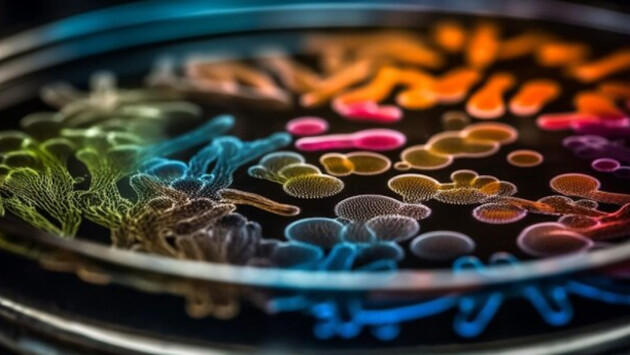

Включение ферментов в полисахаридный гель улучшило их свойства и увеличило срок хранения
Ученые из Воронежского государственного университета исследовали молекулярные особенности взаимодействия протеолитических ферментов с полимерным гелем из целлюлозы, чтобы понять, как создание такого комплекса влияет на активность и стабильность ферментов. Авторы выяснили, что подобный метод прикрепления или иммобилизации ферментов полимерным гелем увеличивает их активность и стабильность. Сам комплекс может сохраняться в течение 21 дня, не утрачивая своих каталитических свойств. Это позволит эффективнее использовать эти соединения в промышленности и медицине. Исследование опубликовано в журнале International Journal of Molecular Sciences.Ферменты — это белки, которые действуют как биокатализаторы, увеличивая скорость химических реакций во всех живых организмах. В их молекулах есть активный центр — это область фермента, где вещества и подвергаются химическому превращению. Протеолитические ферменты, к которым относятся цистеиновые протеазы, участвуют в расщеплении белков и пептидов. Они широко используются в различных отраслях промышленности. Например, при разработке антибактериальных препаратов и в области косметологии. В биотехнологии и промышленности применяется иммобилизация ферментов — это процесс их прикрепления к поверхности природных или синтетических полимерных материалов. Она позволяет улучшить стабильность и активность ферментов, а также повторно их использовать, что увеличивает эффективность и экономическую выгоду ускоряемых ими процессов.Ученые из Воронежского государственного университета использовали методы инфракрасной спектроскопии и молекулярного докинга, чтобы определить, как взаимодействуют молекулы цистеиновых протеаз (бромелайна, фицина и папаина) с иммобилизирующим агентом — гелем из полимера на основе целлюлозы. Также исследователи измерили протеолитическую активность и стабильность полученных иммобилизованных ферментов.Авторы выяснили, что взаимодействие цистеиновых протеаз с полимерным гелем увеличивает количество химических связей внутри молекулы. Это значительно повышает стабильность иммобилизованных биокатализаторов по сравнению с их обычными аналогами. На 21-й день активность нативных ферментов не превышала 7%, тогда как их иммобилизованный комплекс сохранял более 50% исходной активности. Также создание комплекса с гелем вызвало изменение во вторичной структуре белков. Благодаря этому активный центр ферментов стал более доступен для химических реакций. Это повысило активность ферментов по сравнению с их природными аналогами.Это открытие имеет высокий потенциал для разработки новых методов и технологий в области промышленности и медицины. Использование иммобилизованных цистеиновых протеаз с увеличенной стабильностью и активностью позволяет повысить производительность и экономическую эффективность процессов, связанных с использованием этих ферментов.Автор: Дария Пляченко.Материал подготовлен при финансовой поддержке Минобрнауки России в рамках федерального проекта «Популяризация науки и технологий».